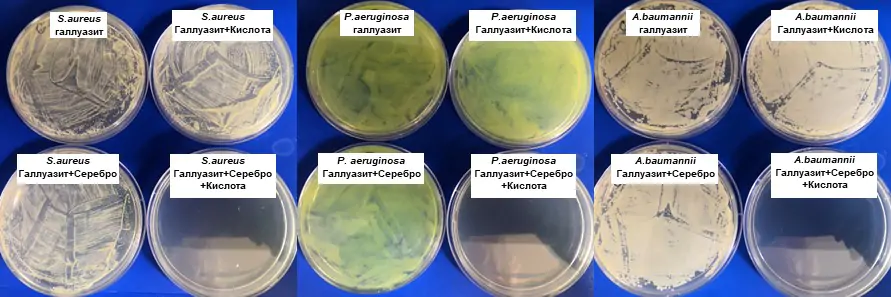
Серебро и кислота помогут бороться с бактериями

Серебро и кислота помогут бороться с бактериями
Российские ученые совместно с бразильскими и китайскими коллегами создали противомикробный материал на основе серебра и кислоты. Его преимущество заключается в том, что он не содержит антибиотиков, а значит, не будет способствовать появлению лекарственной устойчивости у бактерий. Предложенный материал в составе защитных покрытий медицинского оборудования поможет предотвратить распространение внутрибольничных инфекций. Результаты исследования, поддержанного грантом Российского научного фонда (РНФ), опубликованы в журнале ACS Omega.
С каждым годом появляется все больше болезнетворных бактерий с устойчивостью к имеющимся антибиотикам. Хотя ученые и разрабатывают новые препараты, патогены приспосабливаются и к ним. Микробы защищаются разными способами, например, вырабатывают ферменты, разрушающие антибиотик, или изменяют свои молекулы, с которыми лекарство взаимодействует.
Справиться с развитием лекарственной устойчивости можно, если применять альтернативные подходы, к которым микроорганизмы не смогут адаптироваться. Так, один из вариантов — использовать особые материалы, чей механизм противомикробного действия принципиально отличается от такового у антибиотиков. На их основе можно создавать покрытия для предметов, через которые контакт людей неизбежен: мебель, ручки дверей, сантехника, сенсорные экраны и прочее. В результате патогены не будут накапливаться на них и распространяться дальше. Особенно это важно для больниц, где попадание бактерии в организм ослабленного пациента чревато тяжелыми осложнениями и гибелью.
Ученые из Российского государственного университета нефти и газа (национального исследовательского университета) имени И.М. Губкина (Москва) вместе с бразильским и китайскими коллегами предложили новый метод получения антимикробных материалов. За основу авторы взяли серебро и фосфорномолибденовую кислоту. Ионы серебра связываются с ферментами бактерий, нейтрализующими активные формы кислорода, и вызывают гибель клеток из-за окислительного стресса. Кислота подавляет способность бактерий производить защитные ферменты и противостоять действию ионов серебра. Носителем для активных компонентов стал глинистый минерал галлуазит — на поверхность его нанотрубок нанесли наночастицы серебра, а в их полость загрузили кислоту. При этом антимикробный эффект проявлялся только при сочетании компонентов, в то время как по отдельности они не обеспечивали ожидаемого результата.
Антибактериальное действие материала активируется при смачивании — тогда происходит постепенное высвобождение кислоты и ионов серебра. Минимальные количества материала для подавления микробов составили 0,5 г/л для Staphylococcus aureus (золотистый стафилококк), Pseudomonas aeruginosa (синегнойная палочка) и 0,25 г/л для Acinetobacter baumannii («иракибактер», названный так из-за частых инфекций ран военнослужащих США в Ираке). Эти бактерии вызывают внутрибольничные инфекции, в том числе они широко распространены в России.
Хотя измеренные в эксперименте концентрации выше, чем типичные действующие для чистых антибиотиков, разработанные материалы могут быть эффективны для борьбы с бактериями вне организма, а именно для предотвращения их распространения в больницах.
«На исследование нас вдохновили строчки песни Бориса Гребенщикова: "Мы знаем, каково с серебром, посмотрим, каково с кислотой". Полученный материал может быть использован в качестве добавки к защитным покрытиям для медицинской мебели или инструментов. В будущих исследованиях мы планируем изучить антибактериальное действие нашей системы против сформировавшейся биопленки бактерий, поскольку микроорганизмы в ее составе значительно легче вырабатывают устойчивость к антибиотикам», — комментирует один из авторов статьи Андрей Новиков, кандидат химических наук, доцент РГУ нефти и газа (НИУ) имени И.М. Губкина.




